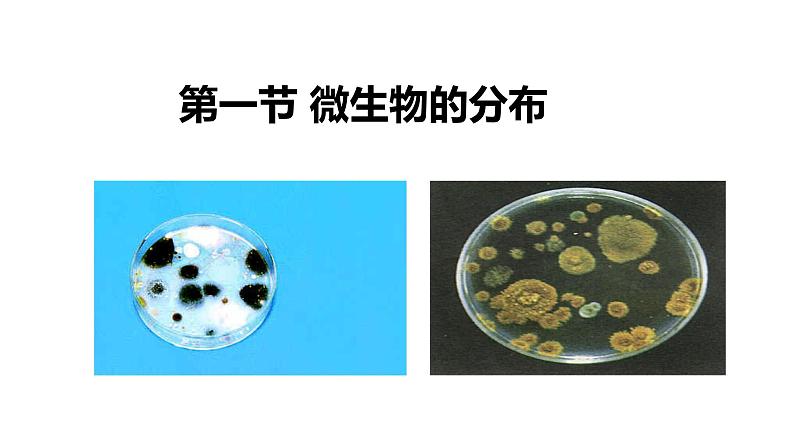
初中  生物  人教版（2024）  七年级上册（2024）第一节 微生物的分布 课件第2页
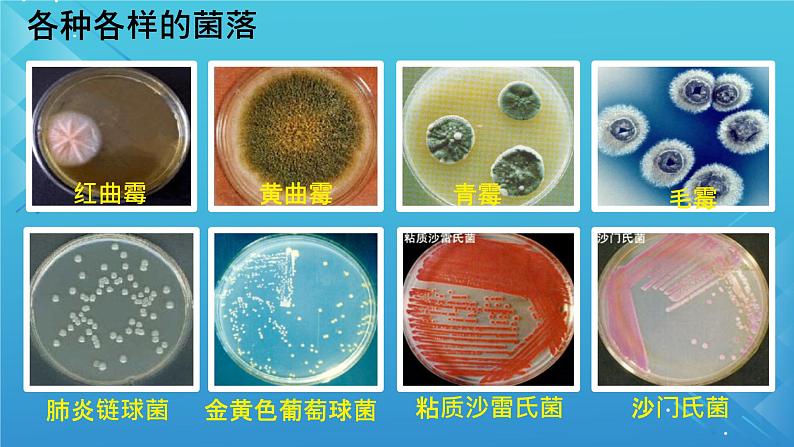
初中  生物  人教版（2024）  七年级上册（2024）第一节 微生物的分布 课件第6页

七年级上册(2024)第一节 微生物的分布获奖课件ppt
展开
这是一份七年级上册(2024)第一节 微生物的分布获奖课件ppt,共26页。PPT课件主要包含了第一节微生物的分布,配制培养基等内容,欢迎下载使用。
微生物:个体微小、结构简单的生物。
菌落:由一个或多个细菌或真菌繁殖后形成的肉眼可见的子细胞群体。
细菌菌落和真菌(以霉菌为例)菌落区别:
表面或光滑粘稠或粗糙干燥
常呈绒毛状、絮状或蜘蛛网状
多为灰色,少数为白色、黄色等,颜色很浅
细菌和真菌培养的一般方法
培养基:琼脂、牛肉汁接种:目的菌转移到培养基
将培养皿和培养基上原有的菌类杀死
4、接种——将少量细菌或真菌放在培养基上的过程
将少量细菌或真菌放在培养基上的过程
5、恒温培养 把接种后的培养皿放在保持恒定温度的培养箱中
防止温度高杀死接种的细菌或真菌
杀死培养基和培养皿上原有的细菌和真菌
培养细菌和真菌的方法步骤
1、为什么培养用的培养皿和培养基,在接种前必须高温处理?为什么要用无菌棉棒?
2、第三条提示相当于细菌、真菌一般培养方法中的哪一个步骤?
相当于一般培养方法中的接种步骤。
3、用无菌棉棒擦拭未洗手的手心,轻轻涂抹在“洗手前”培养基上;洗手后,用无菌棉棒擦拭同一只手的相同位置,涂抹在“洗手后”培养基上;“空白对照”不做任何处理。
3、你认为细菌和真菌的分布情况怎样?
4、细菌和真菌的生活需哪些基本条件?
细菌和真菌几乎无处不在,但在不同环境中分布的多少不同,如手机、百元大钞上附着的细菌和真菌较多。
水分 营养物质 适宜的温度 一定的生存空间
细菌和真菌生活的基本条件
水、营养物质、适宜的温度和一定的生存空间
氧气是不是所有微生物生存的必要条件呢?
乳酸菌是异养厌氧型细菌,加水封口可以营造无氧环境,有利于乳酸菌的生存。
资料:据调查报告:一根筷子上可能有700种细菌!每只脏手可携带40万细菌;而刚洗过的手,每平方厘米亦可检验出3200个细菌;在抽查的700张人民币上,竟有440张检出代表肠道细菌污染的大肠杆菌;每1平方厘米面积的皮肤表面大约含有1~10万个细菌,一个指甲缝里有近5万个细菌!那么,细菌和真菌都能分布在什么环境中呢?
相关课件
这是一份初中生物人教版(2024)七年级上册(2024)第一节 微生物的分布优质课件ppt,共28页。PPT课件主要包含了学习目标,思考讨论等内容,欢迎下载使用。
这是一份初中生物人教版(2024)七年级上册(2024)第一节 微生物的分布精品ppt课件,共17页。PPT课件主要包含了第三章微生物,学习目标,观察菌落,练习与应用等内容,欢迎下载使用。
这是一份人教版(2024)七年级上册(2024)第二单元 多种多样的生物第三章 微生物第一节 微生物的分布优秀ppt课件,共11页。PPT课件主要包含了观察菌落等内容,欢迎下载使用。










